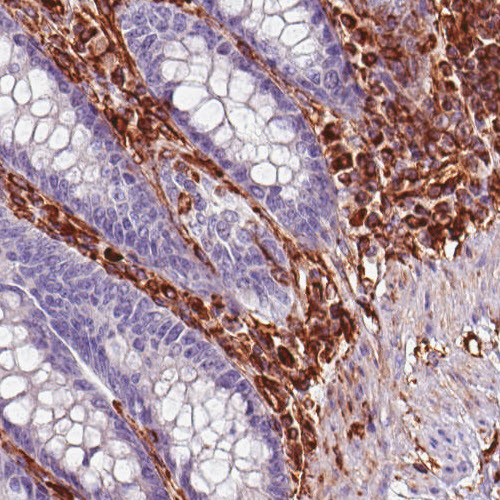

Product Name
Supplier
Clonality
Application
Reactivity
Price
-

Anti CD4 mAb (Clone CL0395, ATL-AMAb90754 w/enhanced validation)
Atlas Antibodies
MonoclonalWBIHCHuman$328.00 - $486.00 -

Anti SDHB mAb (Clone CL0349, ATL-AMAb90708 w/enhanced validation)
Atlas Antibodies
MonoclonalWBICCIHCHuman$395.00 - $554.00 -

Anti SDHB mAb (Clone CL0347, ATL-AMAb90706)
Atlas Antibodies
MonoclonalWBIHCHuman$395.00 - $554.00 -

Anti SDHB mAb (Clone CL0346, ATL-AMAb90705)
Atlas Antibodies
MonoclonalWBIHCHuman$395.00 - $554.00 -

Anti FBLN1 mAb (Clone CL0337, ATL-AMAb90696 w/enhanced validation)
Atlas Antibodies
MonoclonalWBICCIHCHuman$395.00 - $554.00 -

Anti HER2 mAb (Clone CL0268, ATL-AMAb90627)
Atlas Antibodies
MonoclonalWBIHCHuman$328.00 - $486.00 -

Anti RUNX2 mAb (Clone CL0235, ATL-AMAb90594 w/enhanced validation)
Atlas Antibodies
MonoclonalWBICCIHCHuman$328.00 - $486.00 -

Anti RUNX2 mAb (Clone CL0232, ATL-AMAb90591 w/enhanced validation)
Atlas Antibodies
MonoclonalWBICCIHCHuman$328.00 - $486.00 -

-

Anti FBN1 mAb (Clone CL0225, ATL-AMAb90584)
Atlas Antibodies
MonoclonalWBIHCHuman$395.00 - $554.00 -

Anti IDH1 mAb (Clone CL0219, ATL-AMAb90578 w/enhanced validation)
Atlas Antibodies
MonoclonalWBICCIHCHuman$328.00 - $486.00 -

Anti NLRP3 mAb (Clone CL0210, ATL-AMAb90569)
Atlas Antibodies
MonoclonalWBICCHuman$328.00 - $486.00 -

Anti FUS mAb (Clone CL0190, ATL-AMAb90549 w/enhanced validation)
Atlas Antibodies
MonoclonalWBICCIHCHuman$395.00 - $554.00 -
Anti VIM mAb (Clone CL0157, ATL-AMAb90516 w/enhanced validation)
Atlas Antibodies
MonoclonalWBIHCHuman$328.00 - $486.00 -

-

-

-

-

-

-

Anti Vesicular glutamate transporter 2 (Slc17a6/VGluT2) pAb (Guinea Pig, Affinity Purified)
Nittobo Medical
PolyclonalWBHuman$489.00 - $907.00 -

-

Anti Solute Carrier Family 17 Member 7 (SLC17A7/VGLUT1) pAb (Goat, Affinity Purified)
Nittobo Medical
PolyclonalIHCWBMouse$489.00 - $907.00 -

Anti Solute Carrier Family 17 Member 7 (SLC17A7/VGLUT1) pAb (Rabbit, Affinity Purified)
Nittobo Medical
PolyclonalIHCWBMouse$489.00 - $907.00 -

-

-

-

-

-


